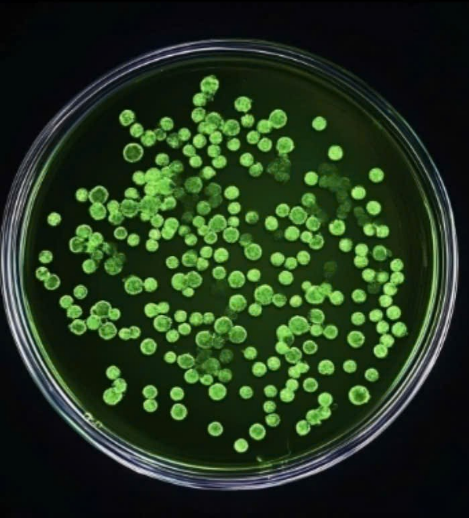
Chiết xuất tế bào gốc từ thực vật

Chọn thực vật tốt cho sức khỏe để sản xuất tế bào gốc
Trong bối cảnh hiện đại, khi nhu cầu về việc chăm sóc bảo vệ sức khỏe từ các sản phẩm tự nhiên ngày càng tăng cao, thì các loài thảo mộc, dược liệu lại càng được biết đến và sử dụng. Hai loại thảo mộc Cỏ ngọt (Stevia rebaudiana) và Tô mộc (Caesalpinia sappan) nổi bật với vai trò quan trọng trong cả y học cổ truyền lẫn đời sống hàng ngày.
![]() |
| Chiết xuất tế bào gốc từ thực vật |
Cây cỏ ngọt ngọt hơn 200 lần đường nhưng không chứa calo
Cỏ ngọt (Stevia rebaudiana) là một loại cây bụi, có nguồn gốc từ Bắc và Nam Mỹ, vị ngọt tự nhiên, nổi tiếng với khả năng thay thế đường trong chế độ ăn uống. Chiết xuất từ lá cỏ ngọt chứa stevioside và rebaudioside, những chất tạo ngọt tự nhiên, ngọt hơn 200 lần so với đường nhưng không chứa calo, phù hợp cho người mắc bệnh tiểu đường hoặc những người muốn giảm cân.
Ngoài khả năng tạo ngọt, các nghiên cứu còn cho thấy cỏ ngọt có nhiều lợi ích sức khỏe:
- Hỗ trợ người bệnh tiểu đường: chất làm ngọt trong cỏ ngọt không cung cấp calo cũng như làm giảm đáng kể lượng đường và mức Insulin sau ăn,giúp điều hòa lượng đường trong máu, làm giảm nhu cầu sử dụng insulin ở những người mắc bệnh tiểu đường.
- Kiểm soát cân nặng: Cỏ ngọt lại là chất làm ngọt tự nhiên không chứa calo và ngọt hơn đường ăn từ 100 đến 300 lần. Do đó, khi sử dụng trong chế độ ăn, cỏ ngọt có thể cân bằng để giúp giảm lượng năng lượng, kiểm soát cân nặng, hỗ trợ giảm cân mà không làm mất đi hương vị của món ăn
Cỏ ngọt là lựa chọn lý tưởng trong các sản phẩm ăn kiêng và hỗ trợ sức khỏe cho người mắc bệnh tiểu đường hoặc béo phì.
- Hỗ trợ huyết áp: Các chất trong cỏ ngọt có khả năng làm giãn nở mạch máu, giúp kiểm soát huyết áp và ngăn ngừa các bệnh liên quan đến tim mạch.
- Hỗ trợ trong việc duy trì sức khỏe răng miệng: Cỏ ngọt giúp làm giảm sự hình thành vi khuẩn trong miệng, khiến nó trở thành một chất phụ gia phổ biến cho kem đánh răng và nước súc miệng, ngăn ngừa sâu răng và viêm lợi,
- Ngăn ngừa loãng xương: Cỏ ngọt có thể hỗ trợ trong việc tăng mật độ khoáng của xương, tăng cường chuyển hóa canxi và điều trị loãng xương dựa trên một nghiên cứu trên động vật.
![]() |
| Chiết xuất tế bào gốc từ cây tô mộc - Ảnh minh họa |
Tô mộc kháng viêm và cầm máu
Tô mộc (Caesalpinia sappan) hay còn gọi gỗ vang là loại cây thân gỗ phổ biến ở nhiều nước Đông Nam Á, bao gồm Việt Nam, được sử dụng trong y học cổ truyền và trong việc nhuộm màu tự nhiên. Dược liệu là phần gỗ của cây, chẻ mỏng và phơi khô, chứa nhiều chất tanin và sắc tố có khả năng kháng viêm, kháng khuẩn và cầm máu.
Tô mộc đã được y học cổ truyền sử dụng từ lâu với nhiều công dụng:
- Chữa bệnh viêm nhiễm và mụn nhọt: Tô mộc có tính kháng khuẩn mạnh, giúp làm sạch vết thương, kháng viêm và nhanh chóng lành da.
- Điều hòa khí huyết: Với tính chất làm tan máu ứ và hoạt huyết, tô mộc thường được sử dụng để điều trị rối loạn kinh nguyệt, kinh nguyệt không đều ở phụ nữ.
- Giảm đau và chống viêm: Chiết xuất từ tô mộc có khả năng giảm đau và kháng viêm, hữu ích trong điều trị các bệnh liên quan đến khớp và viêm cơ.
Tiềm năng và ứng dụng trong thực phẩm và y tế
Tế bào gốc thực vật là một lĩnh vực nghiên cứu nổi bật trong thời đại công nghệ sinh học, mang lại nhiều hứa hẹn trong việc cải thiện sức khỏe và chăm sóc sắc đẹp. Không chỉ giúp tái tạo và bảo vệ tế bào, tế bào gốc thực vật còn được ứng dụng rộng rãi trong các sản phẩm thực phẩm chức năng và y học tái tạo.
Tế bào gốc thực vật rất giàu chất chống oxy hóa, các acid amin, vitamin và khoáng chất có có hoạt tính sinh học cao, có tác dụng nuôi dưỡng và bảo vệ tế bào, giúp chống lão hóa, tăng cường khả năng tái tạo và bảo vệ cơ thể khỏi các tác nhân gây hại.
- Chống lão hóa: Tế bào gốc thực vật giúp tái tạo tế bào, làm chậm quá trình lão hóa và giảm nếp nhăn.
- Chống oxy hóa: Bảo vệ tế bào khỏi tổn thương do gốc tự do, ngăn ngừa lão hóa tế bào và các bệnh thoái hóa.
- Kháng viêm: Giảm viêm nhiễm, hỗ trợ điều trị các bệnh viêm mãn tính.
- Tăng cường miễn dịch: Giúp cải thiện hệ miễn dịch, bảo vệ cơ thể khỏi các tác nhân gây bệnh.
- Hỗ trợ chữa lành vết thương: Kích thích tái tạo mô và phục hồi tổn thương nhanh chóng.
- Ứng dụng trong mỹ phẩm: Giúp cải thiện độ đàn hồi và tái tạo da, làm mịn da và giảm các tổn thương.
Với những lợi ích vượt trội về sức khỏe và sắc đẹp, tế bào gốc thực vật đang mở ra một kỷ nguyên mới trong lĩnh vực chăm sóc sức khỏe toàn diện.
Các nhà nghiên cứu và công ty dược phẩm đang không ngừng khai thác tiềm năng của tế bào gốc thực vật để phát triển các sản phẩm mang tính đột phá, từ thực phẩm chức năng, mỹ phẩm đến các liệu pháp điều trị y học.
PGS.TS Nguyễn Đình Hòa
(Viện trưởng Viện Nghiên cứu ứng dụng Y học tái tạo và Tế bào gốc)